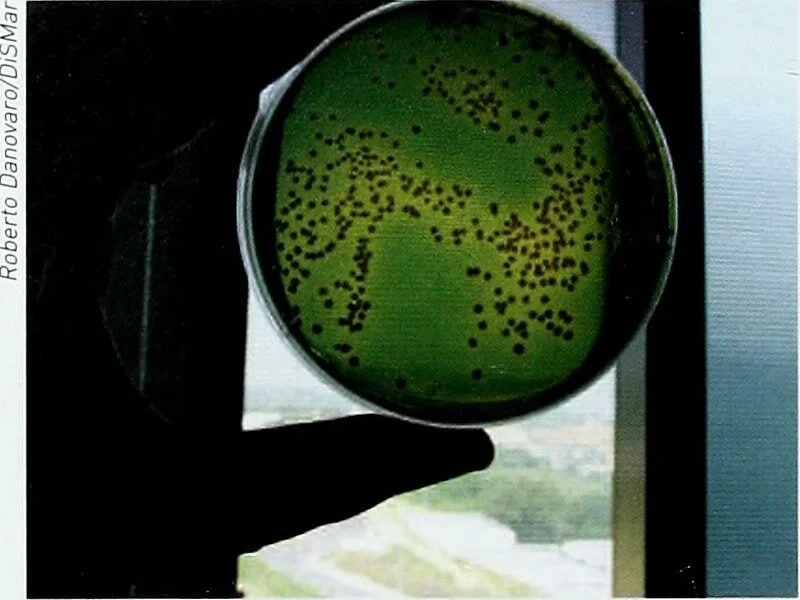

MEDIA
World Animal Day 2023 Manta Rays!
🌊 Dive into the mesmerising world of manta rays on World Oceans Day! In this educational video, we unveil the secrets of these gentle giants—their acrobatic displays, unique markings, and fascinating behaviours. Discover their vital role in maintaining a healthy ocean ecosystem and why their conservation is crucial. Let's celebrate the ocean's wonders and raise awareness for preserving marine life. Join us in honouring World Oceans Day by learning more about these incredible creatures. 🐋✨
Rise Up for The Ocean
Defending the ocean’s function as our life support system and its capacity to produce oxygen, sequester carbon and provide food for billions of people is vital. This cannot wait. Time to #RiseUp4TheOcean riseupfortheocean.org